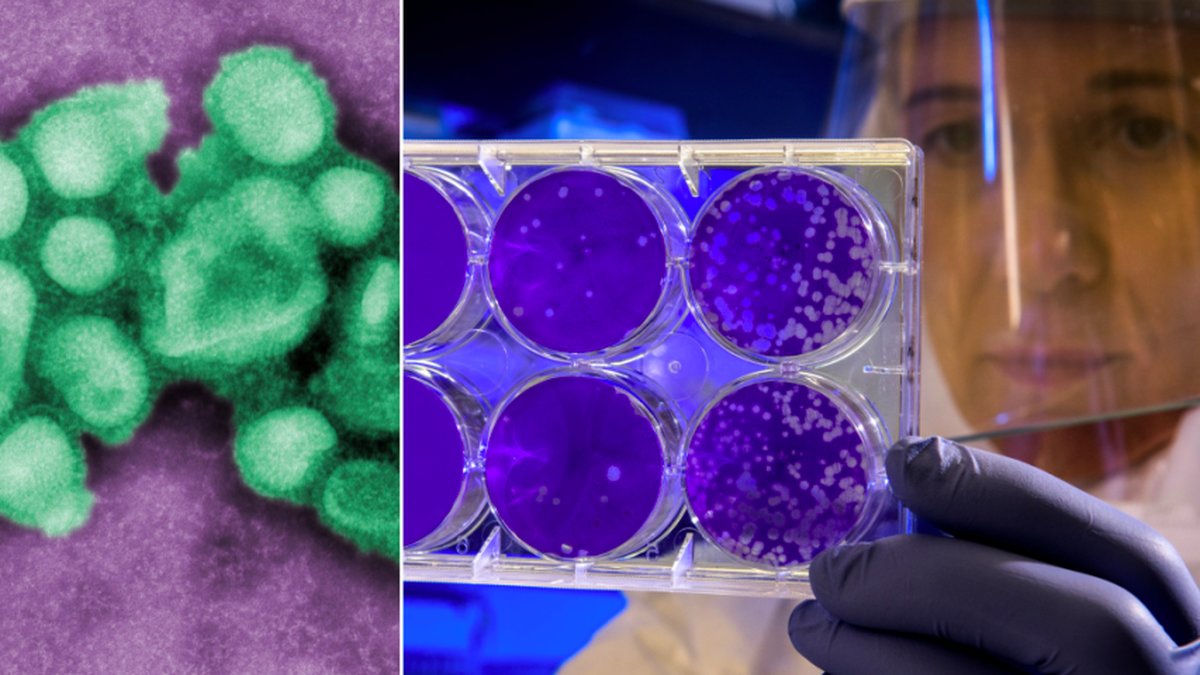
Den första varianten av spanska sjukan har hittats på ett museum i Berlin.

Forskning är en viktig del av samhället och bidrar till att öka kunskapen inom olika områden. Genom forskning kan man undersöka och analysera olika fenomen, problem och frågeställningar för att hitta svar och lösningar.
Forskning bedrivs inom många olika discipliner, såsom medicin, teknik, samhällsvetenskap och humaniora. Forskning är en process som kräver tid, resurser och engagemang, men som också kan leda till banbrytande upptäckter och innovationer.
Forskare använder olika metoder och tekniker för att samla in och analysera data, såsom experiment, observationer, enkäter och intervjuer. Forskning kan vara både kvalitativ och kvantitativ, beroende på syftet och frågeställningen. Forskning är också en viktig del av utbildningssystemet, där studenter lär sig att tänka kritiskt och analytiskt.
Forskning är en global verksamhet som involverar forskare från olika länder och kulturer. Forskning kan också ha en stor inverkan på samhället och påverka politiska beslut och lagstiftning.
Forskning kan också ha etiska och moraliska aspekter, särskilt när det gäller forskning på människor eller djur. Forskning är en viktig del av den vetenskapliga processen och kan bidra till att förbättra människors liv och hälsa, skydda miljön och främja hållbar utveckling.

Alltid aktuella och engagerande nyheter. Dygnet runt, året runt.